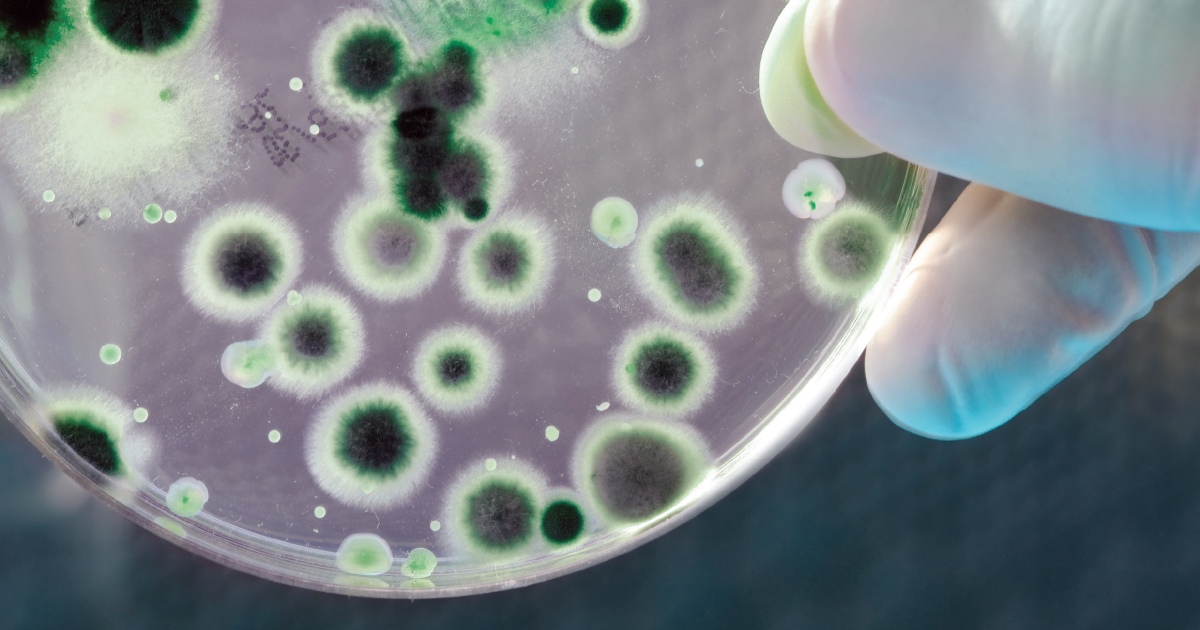
Case Vacanze Les Sources

B&B e case vacanze al miglior prezzo a Lanslebourg-Mont-Cenis
SERVIZI
-
Wi-Fi
-
Non fumatori
-
Animali ammessi
RECENSIONI
-
9+ Eccellente
-
8+ Favoloso
-
7+ Molto Buono
DISTANZA DAL CENTRO
-
Meno di 1 km
-
Meno di 3 km
-
Meno di 5 km
Offerte case vacanze a Lanslebourg-Mont-Cenis
Abbiamo selezionato le migliori case vacanze economiche a Lanslebourg-Mont-Cenis direttamente da privati. Bluepillow ti permette di risparmiare, confrontando le migliori tariffe sui principali siti di case vacanze a Lanslebourg-Mont-Cenis
-
Lanslebourg-Mont-Cenis - Francia
Norberts Place VAL CENIS
- 4 Ospiti 1Camera
13,3 Eccellente (3)Questo appartamento si trova a Val-Cenis. Due delle principali attrazioni naturalistiche della zona sono Parco Nazionale di Vanoise e Lac du Mont Cenis. A livello culturale, invece, spiccano Auditorium ...Verifica disponibilità -
Lanslebourg-Mont-Cenis - Francia
Large comfortable apartment 3 minutes from the slopes and village center
- 5 Ospiti 1Camera
9,4 Eccellente (7)Questo appartamento si trova a Val-Cenis e vanta una posizione strategica in montagna. Auditorium Laurent Gerra e Maison de la Vanoise sono due delle principali attrazioni culturali della zona. Per gli ... -
Lanslebourg-Mont-Cenis - Francia
Superb 2 room apartment (1 bedroom) + mezzanine ...... at the foot of the slopes!
- 6 Ospiti 2Camere
12,3 Eccellente (54)Questo appartamento si trova a Val-Cenis e vanta una posizione strategica in montagna e in riva al fiume. Cabinovia Val Cenis le Haut e TC10 Val Cenis le Haut sono due tappe fondamentali per gli amanti ...Verifica disponibilità -
Lanslebourg-Mont-Cenis - Francia
Very bright duplex located 150 m from the foot of the Val Cenis Lanslebourg slope
- 7 Ospiti 3Camere
9,4 Eccellente (17)Questo complesso di appartamenti si trova a Val-Cenis. Parco Nazionale di Vanoise e Mont-Cenis sono due tappe fondamentali per gli amanti della natura. Tra le altre attrazioni della zona spiccano Maison ... -
Lanslebourg-Mont-Cenis - Francia
Large 110m2 apartment near the slopes
- 10 Ospiti 3Camere
9,8 Eccellente (15)Questo appartamento si trova a Val-Cenis e vanta una posizione strategica in montagna. Redoubt Marie-Thérèse e Forte di Esseillon sono due dei più importanti punti di riferimento della zona, mentre a livello ... -
Lanslebourg-Mont-Cenis - Francia
Rustic apartment on the slopes in cozy Val Cenis
- 18 Ospiti 6Camere
8 Favoloso (4)Situato a Lanslebourg-Mont-Cenis, a soli 14 km dal Lago di Mont-Cenis, l'Apartment Les Alpages. Il De Val Cenis 2 offre sistemazioni con WiFi gratuito. ...Verifica disponibilità -
Lanslebourg-Mont-Cenis - Francia
Apartment Lanslevillard, 1 bedroom, 4 persons
- 4 Ospiti 1Camera
Questo appartamento si trova a Val-Cenis e vanta una posizione strategica in montagna. Redoubt Marie-Thérèse e Forte di Esseillon sono due dei più importanti punti di riferimento della zona, mentre a livello ...Verifica disponibilità -
Lanslebourg-Mont-Cenis - Francia
Apartment Lanslebourg-Mont-Cenis, 1 bedroom, 4 persons
- 4 Ospiti 1Camera
Questo appartamento si trova a Val-Cenis e vanta una posizione strategica nel centro della città e in montagna. Auditorium Laurent Gerra e Maison de la Vanoise sono due delle principali attrazioni culturali ...Verifica disponibilità -
Lanslebourg-Mont-Cenis - Francia
Terrace, ski locker, 23m², Val Cenis
- 4 Ospiti 1Camera
Questo appartamento si trova a Val-Cenis e vanta una posizione strategica in montagna. Auditorium Laurent Gerra e Maison de la Vanoise sono due delle principali attrazioni culturali della zona. A livello ...Verifica disponibilità -
Lanslebourg-Mont-Cenis - Francia
10m from ski slopes, 4th floor, balcony, parking, tv, ski locker, 33m², Val Cenis
- 4 Ospiti 1Camera
Questo appartamento si trova a Val-Cenis e vanta una posizione strategica in montagna. TCD6 Vieux Moulin e Cabinovia Vieux Moulin sono due tappe fondamentali per gli amanti delle attività. Tra le altre ...Verifica disponibilità -
Lanslebourg-Mont-Cenis - Francia
Apartment Lanslevillard, 1 bedroom, 4 persons
- 4 Ospiti 1Camera
Questo appartamento si trova a Val-Cenis e vanta una posizione strategica in montagna. Redoubt Marie-Thérèse e Forte di Esseillon sono due dei più importanti punti di riferimento della zona. E per chi ...Verifica disponibilità -
Lanslebourg-Mont-Cenis - Francia
VVF Val-Cenis Haute-Maurienne *** - 2 Room Apartment 5 People Balcony - Val-Cenis Le Haut
- 5 Ospiti 1Camera
Questo appartamento si trova a Val-Cenis e vanta una posizione strategica in montagna. Cabinovia Val Cenis le Haut e TC10 Val Cenis le Haut sono due tappe fondamentali per gli amanti delle attività. A ... -
Lanslebourg-Mont-Cenis - Francia
T2 - 25m2 - at the foot of the slopes - snow level
- 4 Ospiti 1Camera
13,3 Eccellente (12)Questo appartamento si trova a Val-Cenis. Auditorium Laurent Gerra e Maison de la Vanoise sono due delle principali attrazioni culturali della zona. Tra le altre tappe da non perdere ci sono Centre Aquasportif ...Verifica disponibilità -
Lanslebourg-Mont-Cenis - Francia
Appartement Alliant Confort et Charme au Coeur du Village de Lanslevillard
- 6 Ospiti 2Camere
13,3 Eccellente (9)Questo appartamento si trova a Val-Cenis e vanta una posizione strategica in riva al fiume. Redoubt Marie-Thérèse e Forte di Esseillon sono due dei più importanti punti di riferimento della zona, mentre ...Verifica disponibilità -
Lanslebourg-Mont-Cenis - Francia
Apartment Lanslebourg-Mont-Cenis, 1 bedroom, 5 persons
- 5 Ospiti 1Camera
Questo appartamento si trova a Val-Cenis e vanta una posizione strategica nel centro della città e in montagna. Due delle principali attrazioni naturalistiche della zona sono Parco Nazionale di Vanoise ...Verifica disponibilità -
Lanslebourg-Mont-Cenis - Francia
LARGE 4 STAR APARTMENT 8/10 PEOPLE
- 10 Ospiti 4Camere
9,8 Eccellente (14)Questo appartamento si trova a Val-Cenis e vanta una posizione strategica in montagna e in riva al fiume. Auditorium Laurent Gerra e Maison de la Vanoise sono due delle principali attrazioni culturali ... -
Lanslebourg-Mont-Cenis - Francia
Apartment Lanslevillard, 3 bedrooms, 10 persons
- 10 Ospiti 3Camere
Questo appartamento si trova a Val-Cenis e vanta una posizione strategica in montagna. TCD6 Vieux Moulin e Cabinovia Vieux Moulin sono due tappe fondamentali per gli amanti delle attività. A livello naturalistico, ... -
Lanslebourg-Mont-Cenis - Francia
Apartment Lanslevillard, 1 bedroom, 4 persons
- 4 Ospiti 1Camera
Questo appartamento si trova a Val-Cenis e vanta una posizione strategica in montagna. Auditorium Laurent Gerra e Maison de la Vanoise sono due delle principali attrazioni culturali della zona. Tra le ...Verifica disponibilità -
Lanslebourg-Mont-Cenis - Francia
Apartment for 4 people on the slopes
- 4 Ospiti 2Camere
13,1 Eccellente (30)Questo appartamento si trova a Val-Cenis e vanta una posizione strategica in montagna e in riva al fiume. Auditorium Laurent Gerra e Maison de la Vanoise sono due delle principali attrazioni culturali ...Verifica disponibilità -
Lanslebourg-Mont-Cenis - Francia
Appartement Lanslevillard, 3 pièces, 6 personnes - FR-1-508-214
- Hotel
8 Favoloso (3)L'Appartement Lanslevillard, 3 pièces, 6 personnes - FR-1-508 offre alloggi a Lanslevillard, a 1,8 km da Val Cenis. Questa struttura offre l'accesso a un balcone, un parcheggio privato gratuito e la connessione ...
Agriturismo o Hotel? Scegli tra le offerte migliori
Scegli l’alloggio fatto su misura per te per la tua prossima vacanza: dormire in agriturismo o dormire in Hotel?
-
![Agriturismi a Lanslebourg-Mont-Cenis]() Agriturismi a Lanslebourg-Mont-Cenis
Agriturismi a Lanslebourg-Mont-Cenis -
![Hotel a Lanslebourg-Mont-Cenis]() Hotel a Lanslebourg-Mont-Cenis
Hotel a Lanslebourg-Mont-Cenis
Dove dormire a Lanslebourg-Mont-Cenis
In una destinazione come Lanslebourg-Mont-Cenis sarà possibile trascorrere un soggiorno gradevole. Alloggi vacanza? Lanslebourg-Mont-Cenis offre svariate alternative di alloggi, che rispondono alle esigenze di tutti: sia per chi viaggia in gruppo, in coppia, in famiglia o chi decide di viaggiare da solo.
Su un totale di 910 alloggi, si possono distinguere 855 appartamenti, 56 hotel, 68 case indipendenti, 11 ville, 1 agriturismi, 1 ostelli e molto altro ancora. Ognuna di queste alternative dispone di una notevole gamma di servizi che renderanno più gradevole il vostro soggiorno tra le quali potrete scegliere. I migliori servizi offerti negli alloggi di Lanslebourg-Mont-Cenis sono: Animali ammessi, Piscina, Cucina, Spa e Parcheggio.
I turisti di tutto il mondo apprezzano Lanslebourg-Mont-Cenis. Vorresti sapere quali sono I migliori alloggi con le migliori recensioni a Lanslebourg-Mont-Cenis? Le migliori tipologie di alloggi secondo i viaggiatori sono Alloggi vacanza. Prova ne è la gran quantità di recensioni che ognuno di loro ha scritto. 1.405 recensioni con un punteggio 10.0 Eccellente e 2.404 recensioni con punteggio 8.0 Molto buono, su un totale di 5.116 recensioni.
- Qui potrai trovare i Migliori alloggi a Lanslebourg-Mont-Cenis
- I migliori appartamenti a Lanslebourg-Mont-Cenis
- I migliori B&b a Lanslebourg-Mont-Cenis
- I migliori Hotel a Lanslebourg-Mont-Cenis
- Le migliori case indipendenti a Lanslebourg-Mont-Cenis
- I migliori agriturismi a Lanslebourg-Mont-Cenis
- Le migliori ville a Lanslebourg-Mont-Cenis
- Le migliori tariffe low cost a Lanslebourg-Mont-Cenis
Lanslebourg-Mont-Cenis: Organizzare una vacanza trovando le tariffe migliori per il tuo alloggio
Sulla destinazione Lanslebourg-Mont-Cenis sarà possibile trovare delle soluzioni di alloggi ad una tariffa media pari a 125 euro a notte.
I luoghi d'interesse e cosa vedere a Lanslebourg-Mont-Cenis durante la tua vacanza
I migliori alloggi a Lanslebourg-Mont-Cenis si trovano vicino ai maggiori luoghi d'interesse.
A pochi km dal centro potrai trovare 910 alloggi disponibili con le migliori tariffe: 855 Appartamenti, B&B, 56 Hotel, e molto altro ancora.
Qui di seguito i migliori appartamenti a pochi km dal centro.
- I migliori alloggi vicino ai migliori luoghi d'interesse a Lanslebourg-Mont-Cenis
- I migliori appartamenti
- I migliori B&b
- I migliori Hotel
- Le migliori case indipendenti
- I migliori agriturismi
- Le migliori ville
- Le migliori tariffe low cost per alloggi a Lanslebourg-Mont-Cenis vicino ai migliori luoghi d'interesse
Lanslebourg-Mont-Cenis ed il periodo con il clima migliore per una vacanza
Se invece siete amanti del freddo il mese con le temperature più fredde è il mese di gennaio, dove si raggiungono -8°C.
Mediamente nella destinazione Lanslebourg-Mont-Cenis troverete una temperatura media di 1°C.